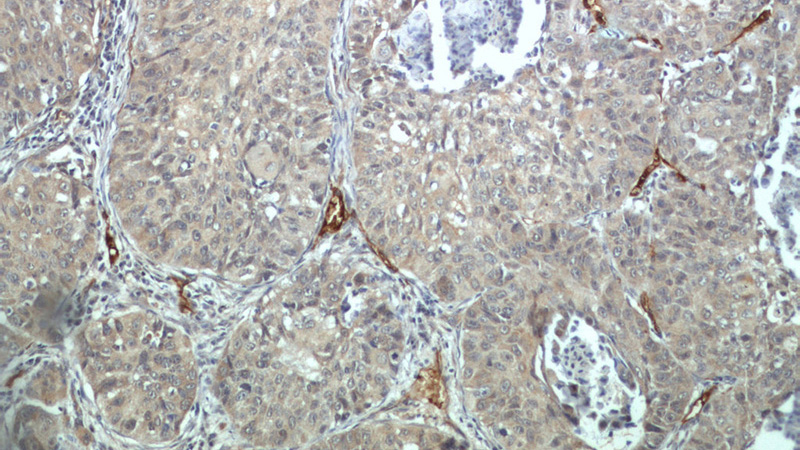
Immunohistochemical of paraffin-embedded human lung cancer using Catalog No:115942(CD248 antibody) at dilution of 1:100 (under 10x lens)
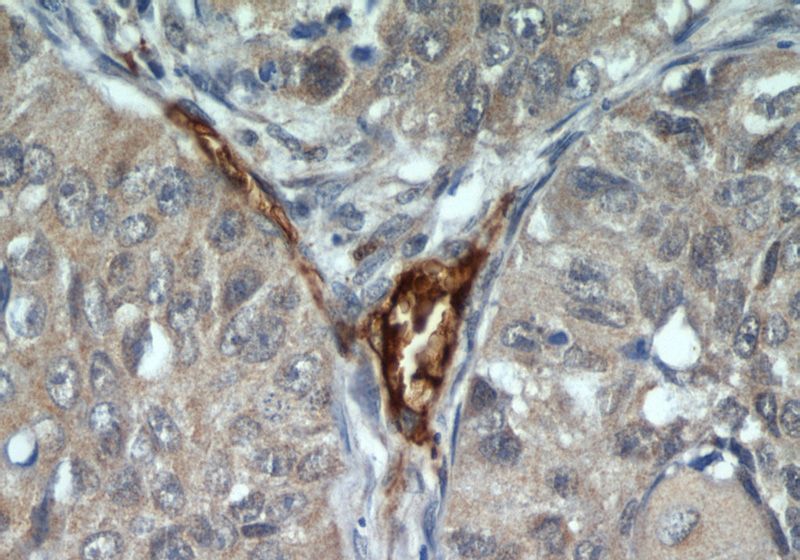
Immunohistochemical of paraffin-embedded human lung cancer using Catalog No:115942(CD248 antibody) at dilution of 1:100 (under 40x lens)

-
Product Name
TEM1 antibody
- Documents
-
Description
TEM1 Rabbit Polyclonal antibody. Positive WB detected in HeLa cells, A375 cells, COLO 320 cells, HEK-293 cells, mouse colon tissue, mouse heart tissue, mouse stomach tissue, NIH/3T3 cells, SH-SY5Y cells. Positive FC detected in HeLa cells. Positive IHC detected in human lung cancer tissue, human gliomas tissue, human renal cell carcinoma tissue. Observed molecular weight by Western-blot: 81 kDa
-
Tested applications
ELISA, IHC, FC, WB
-
Species reactivity
Human,Mouse,Rat; other species not tested.
-
Alternative names
CD164L1 antibody; CD248 antibody; CD248 molecule antibody; endosialin antibody; Endosialin antibody; TEM1 antibody; Tumor endothelial marker 1 antibody
-
Isotype
Rabbit IgG
-
Preparation
This antibody was obtained by immunization of TEM1 recombinant protein (Accession Number: NM_020404). Purification method: Antigen affinity purified.
-
Clonality
Polyclonal
-
Formulation
PBS with 0.02% sodium azide and 50% glycerol pH 7.3.
-
Storage instructions
Store at -20℃. DO NOT ALIQUOT
-
Applications
Recommended Dilution:
WB: 1:200-1:2000
IHC: 1:20-1:200
-
Validations

HeLa cells were subjected to SDS PAGE followed by western blot with Catalog No:115942(CD248 antibody) at dilution of 1:500
Immunohistochemical of paraffin-embedded human lung cancer using Catalog No:115942(CD248 antibody) at dilution of 1:100 (under 10x lens)
Immunohistochemical of paraffin-embedded human lung cancer using Catalog No:115942(CD248 antibody) at dilution of 1:100 (under 40x lens)

1X10^6 HeLa cells were stained with 0.2ug CD248 antibody (Catalog No:115942, red) and control antibody (blue). Fixed with 90% MeOH blocked with 3% BSA (30 min). Alexa Fluor 488-congugated AffiniPure Goat Anti-Rabbit IgG(H+L) with dilution 1:1000.
-
Background
TEM1 (Tumor endothelial marker 1), also named as CD248, Endosialin and CD164L1, is a C-type lectin-like domain (CTLD) containing type I transmembrane glycoprotein. It is now considered to be a highly selective marker for activated perivascular and stromal cells, detected in most cancers and at least some inflammatory disorders. CD248 plays a role in tumor angiogenesis. It is a potential diagnostic tool and therapeutic target of inflammatory and malignant disease. Two isoforms of human TEM1 exist. The calculated molecular weights of the two isoforms are 81 kDa and 46 kDa, respectively. Native TEM1 can be glycosylated, and the glycosylated form has a larger apparent molecular weight than 81 kDa.
-
References
- Rosu-Myles M, She YM, Fair J. Identification of a candidate proteomic signature to discriminate multipotent and non-multipotent stromal cells. PloS one. 7(6):e38954. 2012.
- Suresh Babu S, Valdez Y, Xu A. TGFβ-mediated suppression of CD248 in non-cancer cells via canonical Smad-dependent signaling pathways is uncoupled in cancer cells. BMC cancer. 14:113. 2014.
Related Products / Services
Please note: All products are "FOR RESEARCH USE ONLY AND ARE NOT INTENDED FOR DIAGNOSTIC OR THERAPEUTIC USE"
